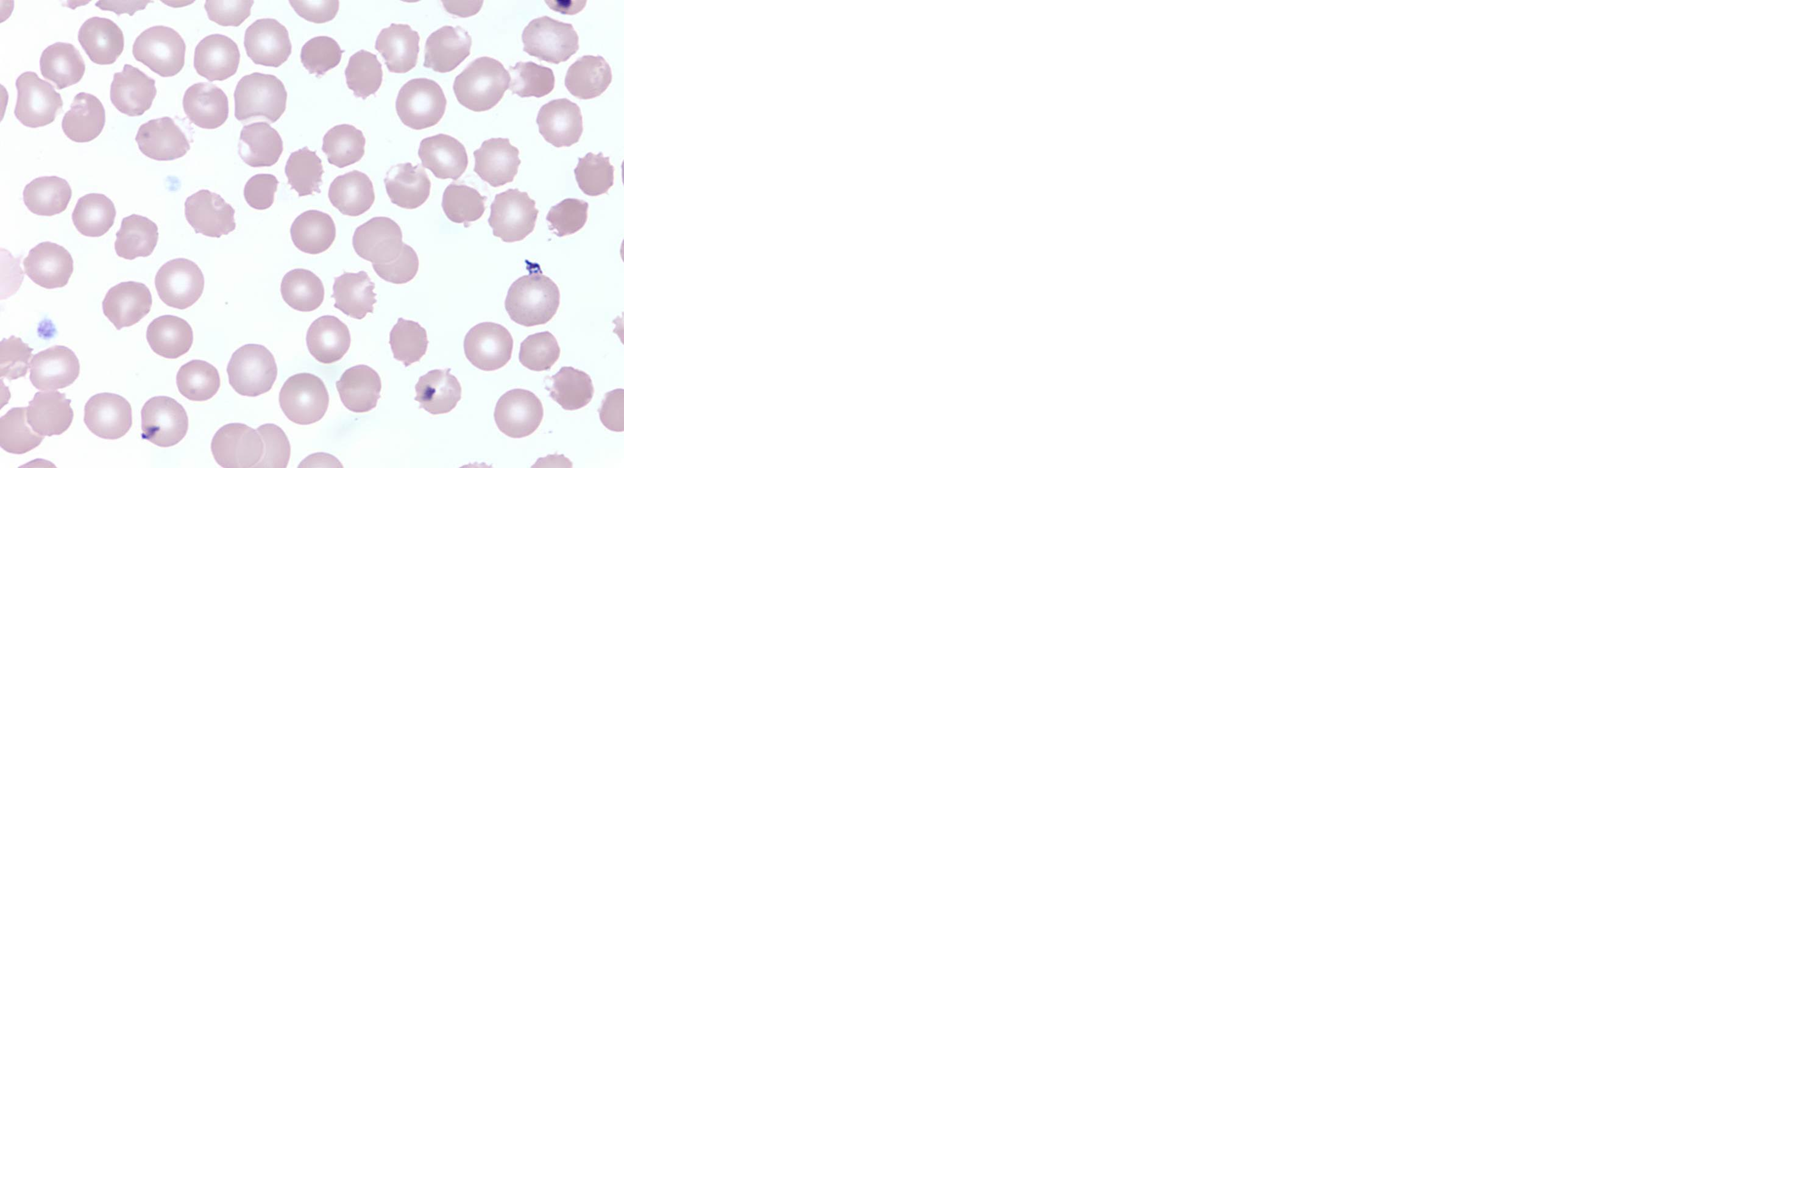
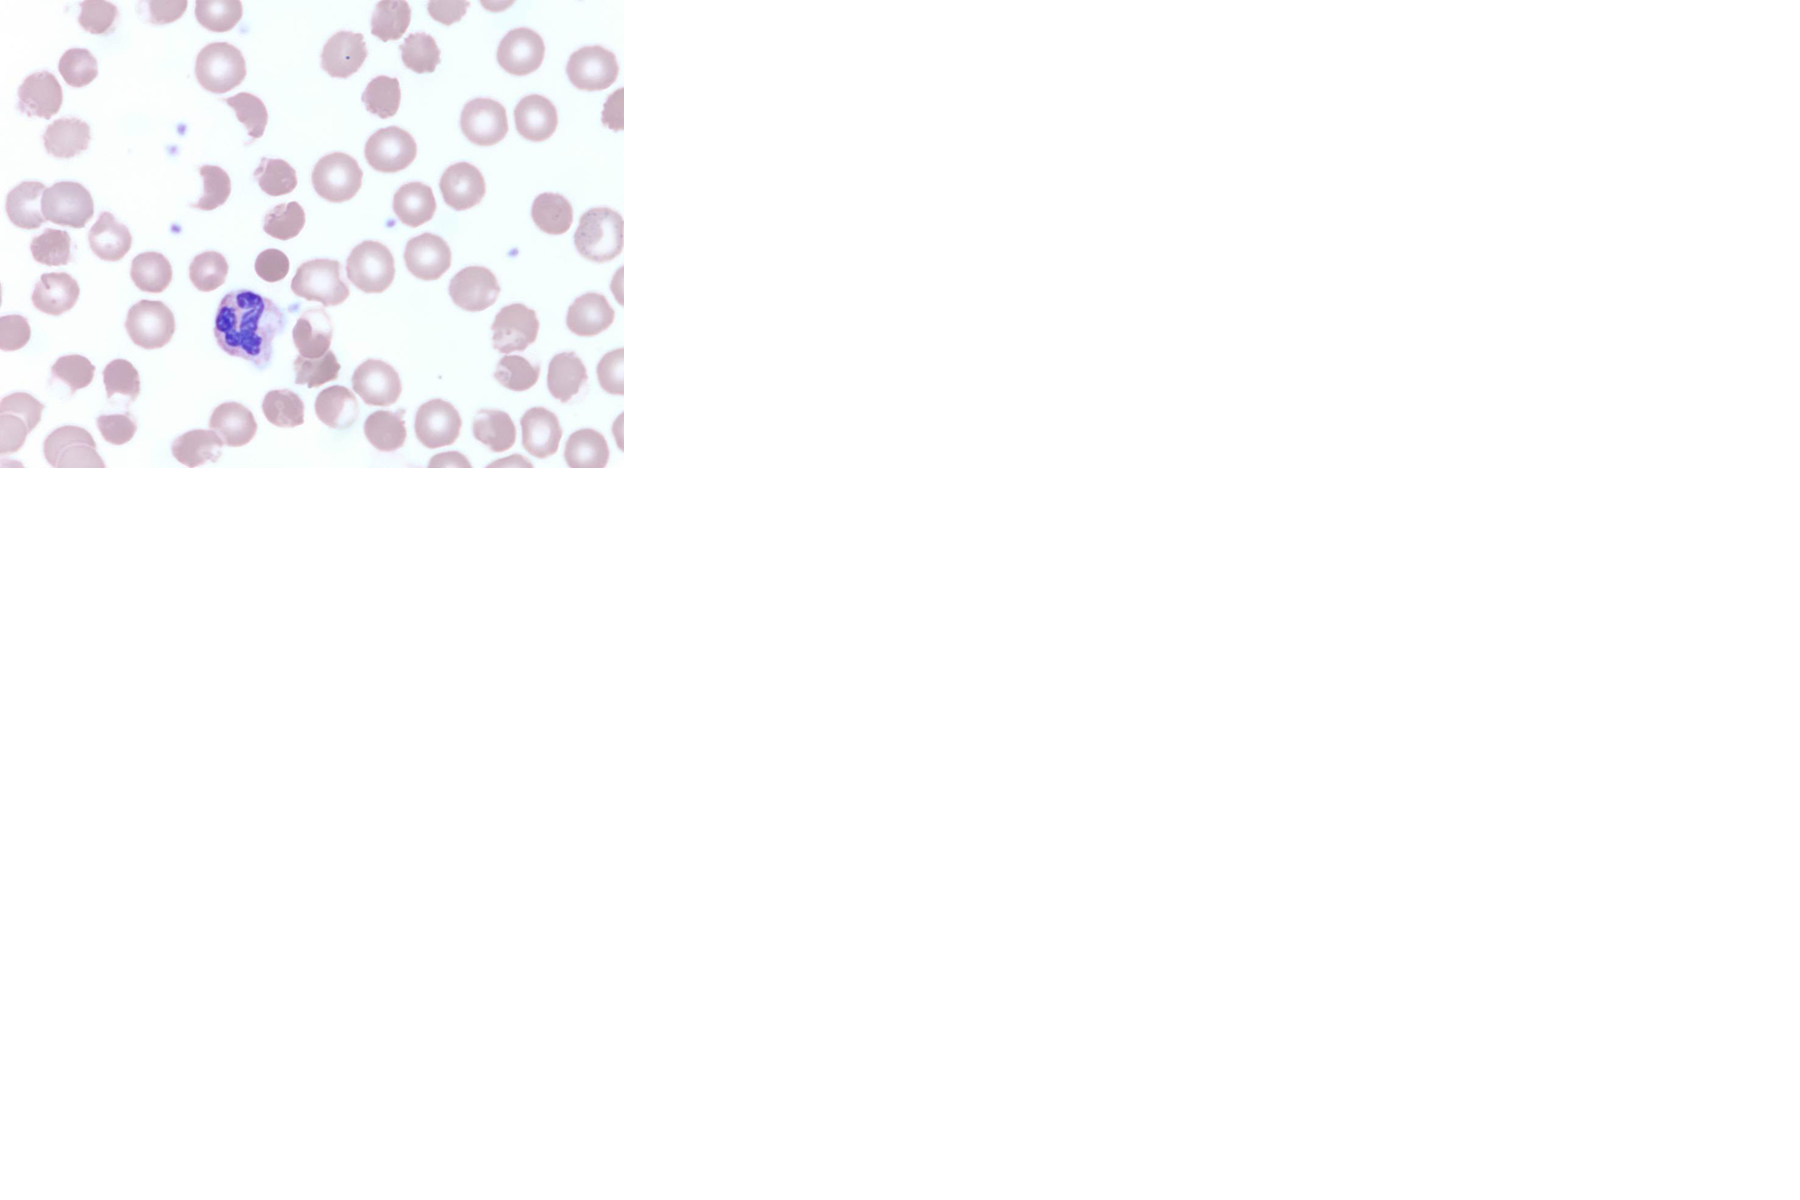

Case Presentation: A 42-year-old Vietnamese-American gentleman presented to the Emergency Department with generalized fatigue and intermittent dark urine for 1 week and fever, chills, vomiting and loose black stools for 1 day. He denied any rash, joint pain, strenuous exercise, recent travel or trauma, new medications or supplements and tick or mosquito bites. There was no history of valve replacement surgeries. Physical examination revealed icteric sclera and jaundiced skin. Pertinent labs included hemoglobin 9.7 g/dL with reticulocyte production index of 1.7 %, total bilirubin 5.2 mg/dL, direct bilirubin 0.7 mg/dL, lactate dehydrogenase 544 IU/L (normal: 94-202 IU/L) and haptoglobin 18 mg/dL (normal: 36 – 195 mg/dl). Urinalysis showed large amount of blood but no red blood cells on microscopy. Peripheral blood smear revealed bite cells, blister cells and polychromasia consistent with hemolysis. Direct Coombs test was negative. Blood smear for parasites, monospot test and heavy metal screen were negative. His hemoglobin dropped to 5.7 mg/dl and he was transfused 2 units of packed red blood cells. G6PD level was < 0.3 U/g Hb (normal: 8.8-13.4 U/g Hb). On revisiting the history, he mentioned increased consumption of Chinese bitter melon tea for his hyperlipidemia for 11 days prior to hospitalization. The patient’s symptoms improved with supportive care, his hemoglobin stabilized, and he was discharged with a list of foods and medications to avoid.
Discussion: Glucose-6-phosphate dehydrogenase (G6PD) deficiency is the most common enzyme deficiency in humans, affecting 400 million people worldwide. While a number of drugs, foods and chemicals can trigger hemolysis in G6PD deficient individuals, the association between herbal and dietary supplements and hemolysis is not clear. Bitter melon seeds contain vicine-like compounds which can induce favism. The severity of hemolytic anemia varies among individuals with G6PD deficiency and can be diagnostically challenging. Patient education regarding safe and unsafe food and medications is the cornerstone in preventing further episodes of hemolysis.
Conclusions: Hospitalists should obtain a detailed history including all herbal and nutritional supplements, including bitter melon, to identify rarer causes of favism in susceptible individuals presenting with hemolysis.